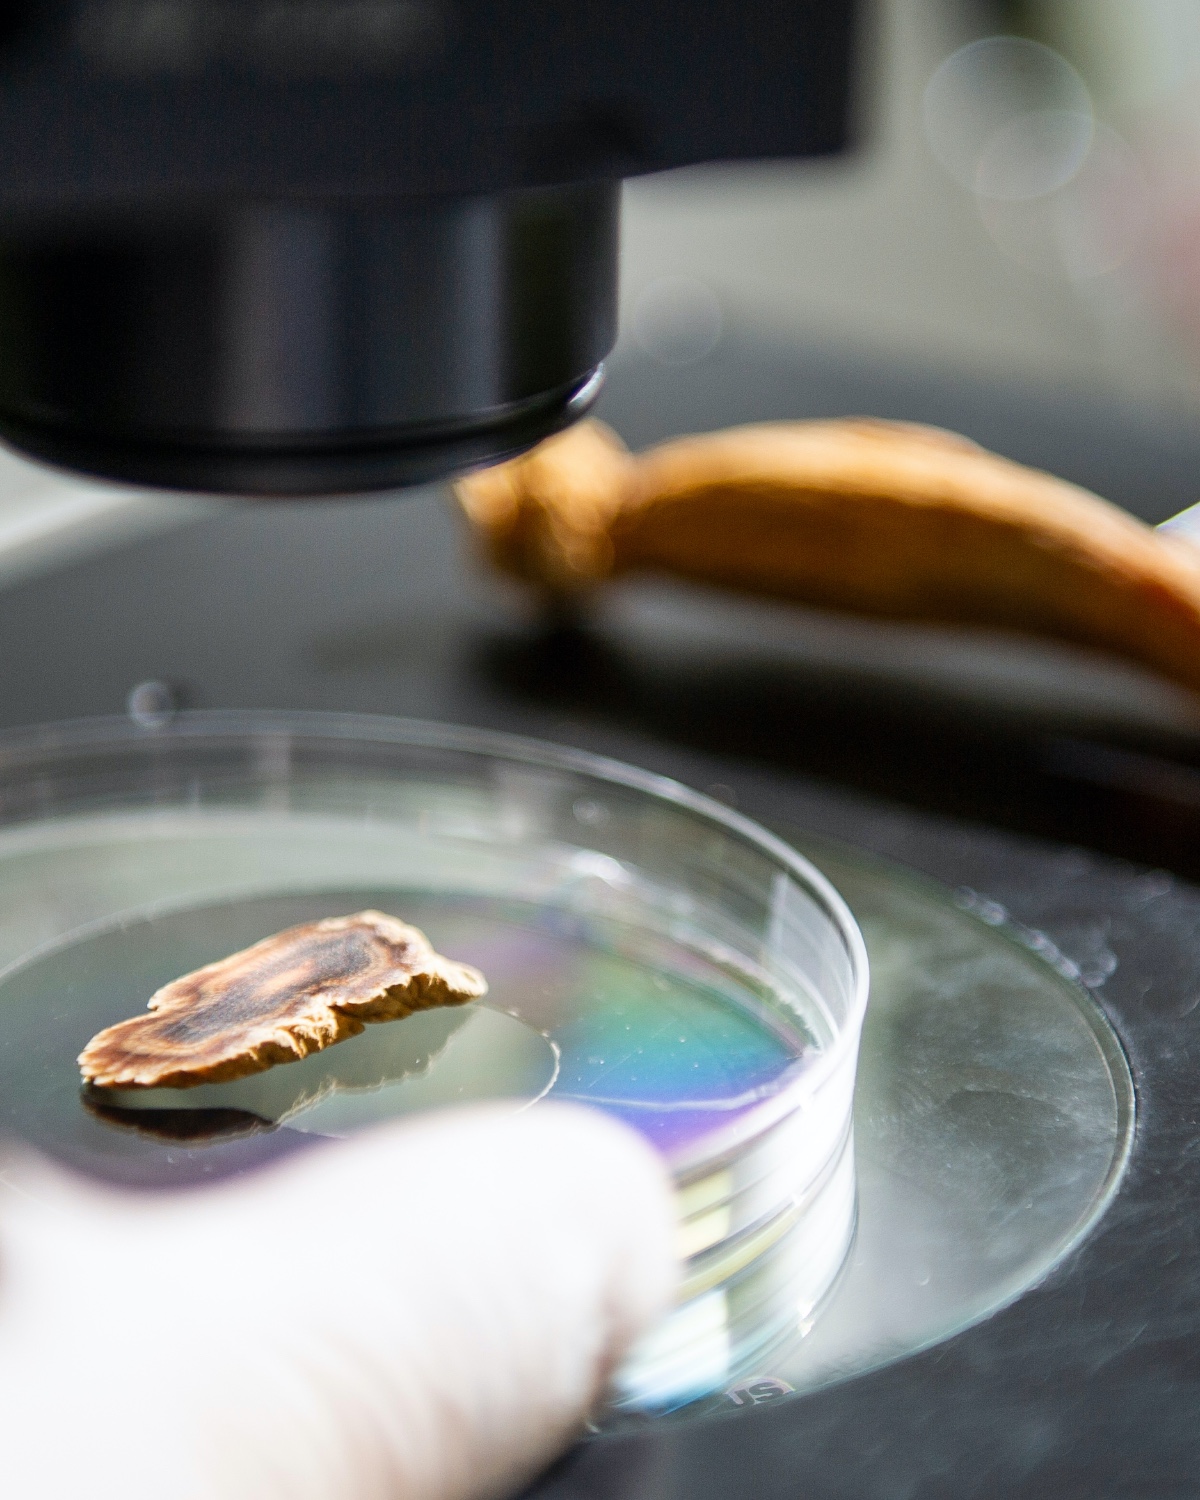

간편하고 효율적인 나의 일상 건강 루틴을 위한
힘이 필요한 모든 순간,
진짜 나를 위해 1포 하라!
직장인들의 애환을 대변해 주는 브랜드에서
힘이 필요한 순간에 함께하는 라이프스타일브랜드를 한 차원 더 확장했습니다
모든 분들의 라이프스타일에 닿을 수 있도록한 발 더 앞으로 나아갑니다
쉽고 빠르고 간편하게
언제 어디서나
그 어떤 상황에서도 유연하게 즐깁니다
쉽고 빠르고 간편하게
언제 어디서나
그 어떤 상황에서도 유연하게 즐깁니다
트렌디한
라이프스타일,
이제 당신 차례

2012년 출시 이후, 에브리타임은 홍삼의 섭취 및 편의 경험을 개선하였고, 전세계 모든 사람들이 트렌디한 라이프스타일을 경험하도록 더 완성도를 높일 것 입니다
나의 평범한 일상도, 특별한 일상도 소중하니까!
숨쉬듯이 자연스럽게,
활력 챙기기
간편한 섭취를 통해, 자연스럽게 만들어진 활력은
더 단단한 내면을 갖추고,
활력을 갖춘 사람은 어디서나 당당하며 활기찬 하루를 완성합니다


하루의 시작을 어느새,
에브리타임 에서
에브리타임
일상에서 가볍게 쭉!
홍삼을 슬림한 액상스틱에 담아
효율적이고 간편한 일상 건강관리를
제공합니다.
에브리타임 필름
슬림하고 간편하게 착-붙!
홍삼을 초경량 구강용해성필름
(Oral Dissolving Film)에 담아 가볍고
간편한 일상 건강관리를 제공합니다.
에브리타임 샷
간편하게 톡!
하루 원샷으로 당신의 활기찬 일상과
간편한 건강습관을 응원합니다.











